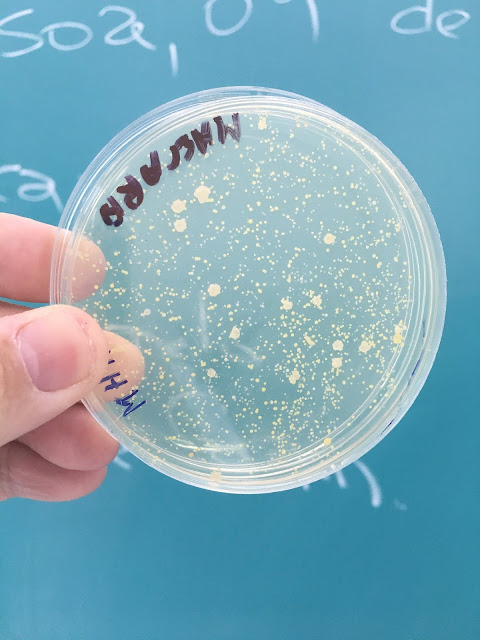
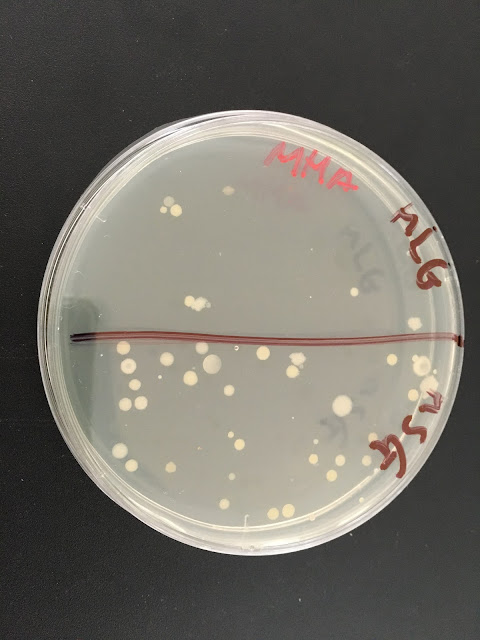

Realizamos no dia 18/08/2021 para a Farmácia, e no dia 02 de setembro de 2021 para o curso de Biologia, nossas primeiras aulas práticas desde 11 de março de 2020, quando a OMS declarou o estado de pandemia pelo novo coronavírus, o SARS-CoV-2. Na primeira aula apresentamos as principais normas de segurança utilizadas num laboratório de microbiologia; as manobras assépticas de acordo com a Escola de Pasteur *; além , é claro, da técnica de lavagem das mãos. e por fim, os alunos foram treinados para realizarem o isolamento de culturas puras através da técnica do esgotamento* em meios sólidos.
* Pasteur e Koch, os fundadores da Nova Ciência, a Bacteriologia, nos ensinaram a trabalhar da seguinte forma: a) as mãos devem ficar na frente do Bico de Bunsen (utilizando essa área de segurança), e não atrás; b) durante as manobras assépticas o operador deve ser responsável pelo seu trabalho, não cabendo a presença de nenhum auxiliar para abrir a placa, ou qualquer outra operação na zona de segurança. Algumas observações devem ser feitas ainda: 1. a menos estejamos com material clínico (p. ex. urina), não devemos usar luvas; 2. antes de iniciarmos os trabalhos na frente do bico, devemos lavar as mãos; 3. se utilizarmos o álcool para assepsia das mãos, o mesmo deverá ficar distante dos bicos.
** Esgotamento: Consiste em espalhar, com auxílio de alça de inoculação, uma porção da suspensão de microrganismos na superfície de um meio de cultura em placa, em 3 setores distintos, segundo a figura abaixo, de modo que a quantidade de material contida na alça seja progressivamente menor. Desta maneira, ao final do procedimento, as células microbianas contidas na alça irão se depositar na superfície do meio, separadamente uma das outras. Após incubação por um tempo e temperatura adequados, cada célula isolada dará origem a uma colônia isolada.
 *Microbiologista trabalhando de acordo com a Escola de Pasteur. Operador com as mãos na frente do Bico de Bunsen.
*Microbiologista trabalhando de acordo com a Escola de Pasteur. Operador com as mãos na frente do Bico de Bunsen.
**técnica do esgotamento - a alça não deve repetir as posições por onde foi passada no meio sólido.
Para verificarmos a presença de micróbios no ambiente e nas superfícies utilizamos swabs* umedecidos em condições assépticas (hastes flexíveis longas, semelhantes à cotonetes com algodão em uma das pontas, em contato com água esterilizada) e esfregamos esses swabs em diversas superfícies, como maçaneta, vaso sanitário, couro cabeludo, bebedouro, cavidade oral, couro cabeludo, óculos e bancada de restaurante; e a seguir, em diferentes placas de Petri contendo meios de culturas sólidos (ágar MacConkey ou Mueller Hinton), utilizando os swabs, semeamos de maneira homogênea e confluente toda a superfície do meio. Veja esquema abaixo.
* alça com ponta de algodão
Na próxima aula verificaremos se houve crescimento microbiano nos meios de cultivos; e se assim ocorrer, procederemos a coloração das colônias (culturas puras) pelo método de Gram.
Discentes da esquerda para a direita: Luís, Maria Miguel, Camilla, Ludmila, Bianca e Bruno. Curso de Farmácia.
Discentes da BIOLOGIA: Thialisom, Maria Pizzo (Bia), Maria Eduarda, Joyce, Mozart, Mateus, Éricka, Samuel e Neto (representante).
Os 9 VALENTES da Biologia.
Após a semeadura das bactérias nos meios de cultivo utilizando o swab, as placas foram colocadas na estufa a 37 ºC. Observe que a placa deve ser sempre colocada na estufa com o meio voltado para cima, a fim de se evitar que água de condensação da tampa da placa de Petri caia em cima da colônia em desenvolvimento (uma cultura pura) e interfira com o seu crescimento, por conta de alteração na pressão osmótica; e que bactérias de colônias próximas se misturem, dificultando o isolamento das mesmas.
Figura: discente Camilla colocando placas semeadas na estufa a 37 ºC. As placas ficarão mantidas nesse ambiente por 48h.
Os microrganismos estão em praticamente todas as superfícies. Nestas condições, eles se apresentam como populações mistas, e para que possamos estudá-los no laboratório necessitamos separá-los em espécies individuais, formando culturas puras. Para isso, utilizamos os meios sólidos para separá-los. O que veremos na próxima aula.
Para o estudo de um microrganismo, precisamos de material e equipamentos especiais no laboratório, além de utilizarmos técnicas específicas, que envolvem, principalmente, esterilização e assepsia.
Antes precisamos definir alguns conceitos utilizados hoje na prática:
CULTURA PURA - uma cultura pura consiste no crescimento, em meio nutritivo adequado, de um conjunto de células idênticas, correspondentes a mesma espécie.
ESTERILIZAÇÃO - A esterilização consiste na eliminação de toda e qualquer forma de vida presente em determinado material ou ambiente.
ASSEPSIA - A assepsia envolve o uso das manobras assépticas, as quais são técnicas que impedem a entrada de microrganismos onde não são desejados.
TÉCNICAS DE MANOBRAS ASSÉPTICAS DESENVOLVIDAS NA AULA
1o - Trabalhar dentro da zona de segurança do bico de Bunsen, ou seja, os recipientes (tubos de ensaio, placas de Petri, etc), com meio de cultura devem ser abertos próximo a chama do bico (NA FRENTE da chama). A alça bacteriológica deve ficar entre a chama do bico de Bunsen e o corpo do bacteriologista (figura a abaixo).
2o - Flambar a alça ou agulha antes e após cada inoculação.
3o- Deixar esfriar o instrumento antes de obter o inóculo, dentro do zona de segurança, preferencialmente na parte interna do recipiente com meio do cultura.
4o - Flambar rapidamente o boca dos tubos contendo microorganismos ou meio estéril, imediatamente após abri-los ou antes de fechá-los. A tampa nunca deve ser colocada sobre a bancada, sendo retirada e mantida segura pelo dedo mínimo da mão direita durante a inoculação.
* As manobras assépticas vão impedir que os microrganismos presentes no ar, ou depositados sobre as várias superfícies junto com a poeira, venham a contaminar materiais estéreis do laboratório tais como meios de cultura, equipamentos, e culturas puras de microrganismos.
Discente Maria Miguel trabalhando de acordo com a Escola de Pasteur; observe suas mãos na frente da chama, o correto.
Foram observados tubos com caldo nutritivo límpidos (esquerda), sem crescimento, e tubos com turvação (direita), demonstrando o crescimento microbiano. Imagem: arquivo pessoal.
Os discentes também visualizaram tubos chamados de ágar inclinado, semeados com bactérias ou não. Observe as estrias de bactérias semeadas, e que após 2 a 4 dias de incubação a 37 ºC, as colônias brancas na superfície do ágar são prontamente visualizadas (tubo da esquerda). No tubo da direita não houve semeadura de microrganismos. Imagem: arquivo pessoal.
Na aula utilizamos o ágar MacConkey. O ágar MacConkey é um meio diferencial seletivo utilizado para o isolamento e diferenciação de bactérias gram-negativas. É possível diferenciar bactérias fermentadoras da lactose (colônias rosáceas), das bactérias não fermentadoras da lactose (colônias incolores).
COMPOSIÇÃO DO MEIO em g/L
Hidrolisado pancreático de gelatina........................ 17.0
Hidrolisado péptico de tecido animal....................... 1.5
Hidrolisado pancreático de caseína ..........................1.5
Lactose ...................................................................10.0
Sais Biliares............................................................. 1.5
Cloreto de sódio...................................................... 5.0
Ágar ...................................................................... 15.0
Cristal violeta........................................................0.001
Água ....................................................................... 1L
pH 7,1 ±0,2 a 25 ºC
O meio permite diferenciar bacilos gram negativos fermentadores de lactose. No processo ocorre a produção de ácido, diminuindo o pH. A presença do indicador vermelho neutro faz com que as colônias lactose positivas exibam uma coloração rosa. Já a presença do cristal violeta e de sais biliares inibem o crescimento dos cocos gram positivos.
Para fixar resolva a questão abaixo:
Inicialmente, o único método existente para a contagem de bactérias ou para o isolamento de culturas puras (clones), era a diluição até a extinção, isto é, até a perda da infecciosidade. Um progresso importante foi a introdução dos meios sólidos por Koch. Os materiais usados eram pouco satisfatórios: a superfície de uma batata cortada podia permitir um crescimento confluente, enquanto que a gelatina permanecia sólida apenas em temperaturas relativamente baixas, sendo liquefeita por muitos microrganismos. Assim sendo, o mundo deve muito a Frau Hesse, esposa de um médico e bacteriologista colaborador de Koch, por ter introduzido o ágar*, um produto japonês, que ela empregava para engrossar as sopas.
* A estrutura fibrosa de um gel de ágar é suficientemente compacta para impedir a movimentação de bactérias no seu interior, mas bastante aberta para permitir a difusão, até mesmo de nutrientes macromoleculares.
Sobre o ágar, suporte utilizado na bacteriologia, é INCORRETO afirmar:
(A) O Ágar é um polissacarídeo ácido obtido de certas algas marinhas; constitui-se primariamente de galactose.
(B) Não é toxico para a bactéria, e muitos poucas conseguem atacá-lo.
(C) Constitui-se primariamente de galactose, com um radical fosfato.
(D) São usados geralmente em concentrações de 15 a 20%.
(E) Certos microrganismos móveis com o Proteus, exigem ágar a 5% para impedir a sua movimentação no meio.
(F) Após a fusão do ágar entre 80 e 100 ° C, as soluções de ágar permanecem líquidas até 45 a 50 ° C, temperatura que muitas bactérias toleram por alguns instantes; após a solidificação em temperatura ambiente, permanecem sólidas até muito acima de 37 ° C.
2a AULA - COLORAÇÃO DE BACTÉRIAS PELO MÉTODO DE GRAM – 23/08/2021
De volta à prática, hoje, segunda-feira, visualizamos as placas de cultivo com meio sólido, semeadas com amostras provenientes das seguintes superfícies: maçaneta, bebedouro, bancada do restaurante, celular, cabelo e vaso sanitário.
Após coloração do esfregaço, obtivemos os seguintes resultados mediante visualização no microscópio ótico comum de campo claro.
Figura: bastonetes Gram-positivos obtidos de swabs esfregados na maçaneta da porta de entrada do Laboratório de Microbiologia. Fonte: Discentes Bianca e Maria Miguel (Objetiva de 100). Observe as regiões não coradas nas extremidades dos bastões. Essas regiões esféricas são áreas densas e portanto com alto índice de refração. Essas estruturas no interior das células são os esporos, do grego semente (endoespóros). Tais estruturas refringentes são produzidas por alguns gêneros bacterianos, como nos bacilos e clostrídios, em respostas às condições inóspitas para a sobrevivência de uma célula típica vegetativa (onde uma gera duas). São extremamente resistentes ao calor, à dessecação, ao congelamento e a ação tóxica de substâncias químicas. São estruturas altamente refratárias, não aceitando corantes como o Gram e o azul de metileno.
ETAPAS DO GRAM
1 2 3 4
1 – Tratar o esfregaço com solução de cristal violeta durante 1 a 2 minutos. Lavar ligeiramente com água e escorrer o excesso. 2 – Cobrir o esfregaço com Lugol por 1 a 2 minutos.
3 – Descorar rapidamente com álcool a 95% - 15 segundos. Lavar ligeiramente com água e escorrer o excesso.
4 – Cobrir o esfregaço com solução de fucsina, durante 15-20 segundos. Lavar. Enxugar com papel de filtro, com cuidado, sem esfregar.
Fonte da imagem: Microbiologia: Tortora, Funke & Case. 12a Edição. Artmed. 2016.
Após preparo do esfregaço (fixação bacteriana na lâmina), inicia-se a coloração. Na etapa (1) adiciona-se o cristal violeta (violeta de genciana) na superfície da lâmina cobrindo todo o esfregaço. Aguarda-se por 1 a 2 minutos. Nessa etapa todas as bactérias serão coradas. Após lavagem cuidadosa da lâmina por meio de uma corrente de água, para retirada do excesso do cristal violeta adiciona-se sobre o esfregaço a solução de Lugol (iodo + iodeto de potássio + água), etapa (2), e é aguardado de 1 a 2 minutos antes de prosseguir. A finalidade da solução de Lugol é fixar o corante na parede celular.
A etapa (3) é dita ser a "alma" do Gram, do método. O tempo de contato entre o esfregaço presente na lâmina e o álcool deve ficar entre 15 e 20 segundos; nada além. É a etapa que irá diferenciar e tornar possível a classificação das bactérias em Gram-positivas ou Gram-negativas. Observe esquema abaixo:
Observe que todas as bactérias ficam azuis ou roxas azuladas, mas o álcool desorganiza a membrana externa das Gram-negativas, fazendo com que o corante cristal violeta se perca na lavagem. Além do mais, o etanol com sua cadeia de C-C ligada a átomos de H, grupo C2H5, possui natureza apolar, dissolvendo assim a lipídica membrana externa.
Na etapa (4) joga-se o contracorante de cor vermelha para contrastar com o azul das roxas azuladas das Gram-positivas. As bactérias que foram descoloridas pela solução de álcool-acetona ficarão vermelhas rosáceas.
Finalmente, com um papel toalha retira-se o excesso de água e observamos o esfregaço corado no microscópio comum de campo claro. Começamos pela objetiva de 10 para visualizar um bom campo com bactérias coradas. Passa para a de 40, para melhorar a visualização do campo, "aproximando" mais as bactérias do observador. E agora, para a objetivo de 100x, adiciona-se sobre o esfregaço um pequena gota de óleo de cedro para o exame final.
Típicos cocos roxos Gram-positivos. Arquivo pessoal.
Veja alguns resultados da prática:
Bastonetes Gram-negativos encontrados no bebedouro.
Bastonetes Gram-positivos com endosporos encontrados na maçaneta da porta de entrada do Laboratório de Microbiologia.
Típicos cocos em cachos Gram-positivos obtidos a partir da tela do celular da discente Camilla.
2a AULA - COLORAÇÃO DE BACTÉRIAS PELO MÉTODO DE GRAM – 09/09/2021 – BIOLOGIA
Realizamos hoje a prática do método de coloração de Gram com a turma de Biologia. Inicialmente observe algumas placas de cultivos semeadas com material colhido utilizando um swab umedecido em água esterilizada.
Cultura a partir de um swab esfregado na máscara de um discente com três dias de uso e sem lavagem. Observe as inúmeras colônias bacterianas que cresceram no ágar Mueller Hinton após 48h de cultivo em estufa a 37 ºC.
Discentes em atividade. Alguns alunos solicitaram que não saíssem seus rostos.
Discente Beatriz feliz com seu desempenho.
Discentes Neto e Eduarda comemorando os seus resultados com o monitor da disciplina Eduardo.
OBRIGADO PELO EXCELENTE DIA QUE VCS ME PROPORCIONARAM. PARABÉNS PELO EMPENHO E DEDICAÇÃO!
"Gostaria de ter tirado as fotos com todos sem máscaras, mas bem sabemos que o momento não permite. Muito embora conheço os rostos de todos vcs, de tal forma que ficarão gravados em minha memória afetiva."
prof Marcelo Moreno
09/09/2021
RESULTADOS DO GRAM
Observe bastonetes detectados na maçaneta da porta do laboratório.
Observe bastonetes detectados no bebedouro do corredor. Perceba que existe um gradiente de cor na imagem. Na parte superior estão mais para o roxo e na parte de cima se apresentam bem rosáceos. O ideal teria sido repetir o Gram.
Duas lâminas da mesma placa de cultura coradas por diferentes alunos. Típicos cocos Gram-positivos roxeados obtidos de cultura da amostra de swabs da unha.
O Prof Marcelo Moreno se enganou com o resultado do Gram dos discentes Neto e Eduarda (acima cumprimentando o professor), retirando seu ponto. Mas prontamente se deu conta da "injustiça acadêmica" que iria cometer e corrigiu ainda em aula, devolvendo toda a pontuação indevidamente sequestrada. Tal registro foi realizado na frente de todos os seus colegas! kkkkkkkkkkkk!!!
LEMBRANDO QUE TODOS LAVARAM AS MÃOS APÓS TÉRMINO DA PRÁTICA!
No final da aula recebi o feedback da aula de hoje de alguns alunos. Veja o conteúdo:
"Simplesmente amei a aula. Acho fundamental o fato do professor, após explicar como devemos realizar as atividades no laboratório, nos deixar bem à vontade para colocarmos o que aprendemos em prática. Também acho uma ótima estratégia de ensino estimular os próprios alunos a auxiliarem os colegas que estão com dificuldades, algo que acrescenta bastante tanto para quem está sendo auxiliado quanto para quem está auxiliando. Os conhecimentos adquiridos hoje com certeza farão total diferença ao longo da minha vida acadêmica e profissional"
3a AULA - CONTROLE DO CRESCIMENTO MICROBIANO – 25/08/2021
Hoje realizamos experimentos para avaliar como substâncias químicas e a temperatura interferem com o crescimento bacteriano.Verificamos a ação de antissépticos* sobre a microbiota presente nas mãos, e ação do calor sobre o Staphylococcus aureus e o Bacillus spp.
* Os antissépticos são produtos químicos (biocidas) utilizados para reduzir e/ou eliminar gérmens presentes na pele ou superfícies.
No final da prática foi realizado o antibiograma; a fim de verificar a susceptibilidade dos microrganismos aos antibióticos. A técnica é baseada na difusão do antimicrobiano no meio de cultivo sólido (o ágar Mueller Hinton foi utilizado).
O procedimento consistiu na inoculação do micróbio (Staphylococcus aureus) na placa do ágar Mueller Hinton de acordo com as manobras assépticas. Para isso preparamos no tubo de ensaio um caldo turvo de bactéria, a partir de uma cultura pura disponível para a prática. Veja figura abaixo:
Discente Ludmila preparando o caldo bacteriano (observe a turvação no fundo do tubo) para ser utilizado no antibiograma.
Após, colocamos o swab em contato com esse líquido turvo, conforme imagem abaixo (vou colocar ainda), e a seguir esfregamos o swab umedecido com esse caldo bacteriano no meio (semeadura da bactéria no ágar Mueller Hinton), conforme figura abaixo.
Esfregando o swab no meio e ao mesmo tempo rodando a placa, a fim de se obter um crescimento homogêneo e confluente.
Após a semeadura da bactéria na placa de ágar, colocamos os discos impregnados com antibióticos com o auxílio de uma pinça. Veja esquema abaixo.
FIGURA ESQUEMÁTICA DO ANTIBIOGRAMA
Avaliar a susceptibilidade de microrganismos a diferentes antibióticos pode ser determinada pela técnica da difusão em placa – o antibiograma. Fonte da imagem: Microbiologia Tortora. Editora ArtMed, 2012.
Resumindo:
Umedecemos em condições assépticas, um "swab" no tubo de caldo simples com o crescimento bacteriano, com ele semeamos toda a superfície da placa de Petri visando um crescimento confluente. Após a semeadura, pegamos, com pinça estéril, os discos de antibióticos e colocamos em espaços equidistantes na superfície do meio (4 por placa). Pressionamos ligeiramente sobre a superfície do ágar, usando a própria pinça. E tomamos cuidado para não "ferir" o ágar. Depois incubamos as placas a 37 °C, com o meio de cultivo voltado para cima cima.
Caldo bacteriano preparado para a semeadura. Não foi utilizada a escala de Mac Farland para padronizar a concentração bacteriana do inóculo (turma de Biologia, 14/09/21).
Umedecendo o swab com o caldo da bactéria para ser analisada quanto a sensibilidade aos antimicrobianos. Pressiona-se o swab contra a parede do tubo para retirar o excesso de líquido (repleto de bactérias). Turma de Biologia, 14/09/21.
Semeando com o swab a bactéria na placa para a realização do antibiograma. Turma de Biologia, 14/09/21.
Após semeadura na placa de cultivo colocou-se os discos de papel impregnados de antibióticos com o auxílio de uma pinça, fazendo um leve pressão para que o disco ficasse preso ao ágar. Turma de Biologia, 14/09/21.
Os discos foram dispostos eqüidistantes um dos outros e a uma distancia das bordas da placa. Se faz necessário para a realização das medidas que serão efetuadas na próxima aula. Turma de Biologia, 14/09/21.
Monitora da disciplina de Microbiologia, Marina, acompanhando o discente do curso de Biologia, Samuel, realizando as manobras assépticas de acordo com a Escola de Pasteur. Turma de Biologia, 14/09/21.
4a AULA - Leitura da aula anterior: CONTROLE DO CRESCIMENTO MICROBIANO – 30/08/2021 – FARMÁCIA
Observe halos de inibição ao redor dos discos. Aula da Farmácia.
Com o auxílio de uma régua medimos o diâmetro do halo de inibição no disco da Vancomicina, potência de 30 µg, e de posse do valor (21 mm) consultamos a tabela para determinar se a bactéria é sensível ou não ao antibiótico. Veja:
Com o auxílio da régua o valor encontrado foi de 2,1 cm (21 mm). E após consulta na tabela abaixo, ficou determinado a sensibilidade do S. aureus frente à vancomicina (tabela a seguir). Trata-se de uma prática tão somente para a aprendizagem do fundamento do antibiograma. Por exemplo, não utilizamos a escala de Mac Farland para padronizar a concentração bacteriana do inóculo.
Fixação do conteúdo:
Assinale a opção que melhor corresponde o valor do diâmetro do halo de inibição de crescimento da última figura da prática, em cm:
(A) 2,1 ± 0,01
(B) 2,1 ± 0,1
(C) 21 ± 1
(D) 2,19 ± 0,01
(E) 2,09 ± 0,01
4a AULA - Leitura da aula anterior: CONTROLE DO CRESCIMENTO MICROBIANO – 16/09/2021
BIOLOGIA
Resultados
Monitora da disciplina de Microbiologia, Marina Coelho, anotando os dados do antibiograma, medidos pelos discentes.
Ação do agente físico temperatura sobre o crescimento de S. aureus.
Ação do agente físico temperatura sobre o crescimento de B. subtilis.
Ação de detergente líquido sobre o crescimento microbiano.
Ação do álcool a 70% sobre o crescimento microbiano.
Ação do álcool iodado sobre o crescimento microbiano.
Ação do álcool-gel sobre o crescimento microbiano.
 |
Antibiograma realizado com o S. aureus (valor 20 mm). Consulte a tabela acima na aula da Farmácia. Medida para a vancomicina potência do disco 30 μg. |
Análise dos resultados discutidos em sala:
1. Temperatura não atingiu 100 ºC, ou se atingiu, a presença do berço de algodão não permitiu um contato homogêneo.
2. Erros do operador.
3. Fabricantes dos agentes químicos.
4. Formação de esporos pelos B. subtilis.
5. Álcool a 70% seja gel ou líquido exigem um tempo mínimo nas mãos para sua ação biocida, além de provavelmente não ser tão efetivo para fungos.
6. Consultando a tabela dos valores dos diâmetros dos halos de inibição do crescimento bacteriano, foi verificado que o S. aureus é sensível a vancomicina.
06/09/2021
Primeira avaliação - FARMÁCIA
Após cerca de 1h e 30 minutos de avaliação, com 16 questões de múltipla-escolha, onde todos realizaram a prova em seus lares, utilizando o MeetGoogle e o WhatsApp para responder, nenhum dos discentes reclamou que a prova foi cansativa. Veja os comentários:
"Foi tranquila , sem imprevistos . O prof. abordou o que apresentou em sala. Acima de tudo a prova foi justa."
Comentou Luís do curso de Farmácia ao final da prova.
xxx
"Eu gostei bastante, foi bem condizente com o que foi dado em sala de aula. Não estou totalmente satisfeita com o meu desempenho, poderia ter sido melhor...
Agora é estudar para melhorar nas próximas avaliações.
Algumas questões que errei fiquei em dúvida, vou conferir com os monitores."
Comentou uma discente da Farmácia
xxx
"foi ótima, dentro do esperado!"
comentou uma discente no término da prova.
Média e desvio padrão: 5,70 ± 0,36
Nota máxima 7.
15/09/2021
Discentes da Farmácia escrevendo relatório final de suas atividades práticas sob a orientação do Professor Marcelo Moreno. Todos mantendo distância mínima de 1,5 m, devidamente resguardados com as normas de biossegurança para o enfrentamento da Covid-19, SARS-2. Imagens permitidas pelos alunos para inclusão no blog, a fim de que a postagem-relatório fosse produzida para aqueles discentes que não podiam assistir às aulas por motivos pessoais.
21/09/2021
Primeira avaliação - BIOLOGIA
Dados ND
01/12/2021
AULA PRÁTICA DE VIROLOGIA
Detecção de antígenos de rotavírus e adenovírus nas fezes de crianças diarreicas na faixa de 0 a 5 anos de idade
Discentes da esquerda para a direita: Ludmila, Maria Gabriel, Bianca, João e Pedro.
Veja detalhes do roteiro da prática em :
https://profmarcelomoreno2010.blogspot.com/2018/05/1a-pratica-de-virologia-no-curso-de_24.html
06 e 07 de dezembro de 2021
3ª AVALIAÇÃO - VIROLOGIA
BIOLOGIA
Média e desvio padrão: 8,00 ± 0,67
Valor máximo 10.
n = 8
FARMÁCIA
Média e desvio padrão: 9,05 ± 0,66
Valor máximo 10.
n = 18
Meus agradecimentos aos Monitores Marina Coelho e Eduardo Amorim. Vcs fizeram um excelente trabalho.
FIM
Uma Nova Esperança
31/03/2022
Finalmente o período (2021.1) passou, e ao entrar em um novo período (2021.2) todos os docentes são avaliados pelos seus alunos de forma que todos ficam no anonimato ( os alunos).
Minha esposa trabalha num serviço voluntário onde alfabetiza crianças de uma comunidade carente na faixa de 9 a 14 anos. Um menino de 12 anos (nome fictício Jules) no 6º ano do Ensino Fundamental não sabe ler, e outro, da mesma idade, mas com 1,5m de altura (nome fictício Juan). Juan provavelmente sofreu com a desnutrição. Jules tem vergonha de não saber ler. Juan é muito agressivo porque os outros meninos zombam dele constantemente.
Hoje, Juan, chegou e não queria fazer nenhuma tarefa de aula. Ficou levantando e saindo da sala. Mas de repente ele volta e senta na cadeira, e muito nervoso diz para a minha esposa:
– Tia, vou fazer com você. Me ensina esse aqui.
Estavam trabalhando as letras S e Z.
Jules que entrou hoje, relatou pra ela:
– A matéria que eu mais gostava é matemática, mas agora é português.
Minha esposa ficou emocionada. Não conteve algumas gotas de lágrimas.
Voltando aos meus queridos alunos, onde muitos já até lecionam Biologia e possuem mais de 50 anos. E como podemos constatar, metade da turma da Biologia nunca esteve presente nas 6 aulas práticas do curso, a outra metade foi sempre assídua. Mas todos completaram a disciplina (ninguém foi reprovado ou mesmo para exame final), pois este relatório de 4 práticas foi disponibilizado para todos. Além de disponibilizar vídeos produzidos por mim mesmo para este momento (1. https://www.youtube.com/watch?v=OBzJ4XBgb08&t=5s , 2. https://www.youtube.com/watch?v=2CoKhAMGkEA ).
Sempre fui assim, aproveitei o máximo de meus alunos, dentro de suas limitações.
Pois bem, os discentes da Biologia avaliaram o meu trabalho ao se inscreverem no novo período, cerca de 75 dias depois do término do período anterior. Metade da turma me avaliou com notas 0, 1 e até 2. A outra metade "viu" 8, 9 e vários 10. Lembre-se, mais da metade dos alunos não não estavam presentes a uma única aula prática!!! Todos têm direito a faltarem até 25% do curso.
O momento foi de ensino híbrido determinado pela universidade (aulas teóricas remotas e aulas práticas presenciais). E houve o seguinte comentário de uma das metades (todos estudando para se formarem como futuros professores de Biologia no país):
"Professor irresponsável, grosseiro, desagradável, insensível com a situação de pandemia fazendo aulas presenciais com presença obrigatória - indo contra normas estaduais, municipais e institucionais. Não sabe apresentar o conteúdo e usa metodos horríveis de avaliação (pelo whatsapp!). Simplesmente uma das minhas (e de toda a turma, consenso generalizado) piores experiências desde que entrei na universidade. Péssimo professor."
Comentário anônimo na avaliação do sistema.
Na turma de Farmácia, durante a primeira avaliação remota percebi uma coincidência. Duas discentes respondiam por último, via WhatsApp, e sempre acertavam ou erravam as mesmas questões. Por conta disso interrompi a prova, comunicando que estava havendo algo anormal e não poderia continuar, justamente para manter a lisura do processo. Visto que no ambiente universitário vagas de monitoria e pesquisa, além de bolsas remuneradas são decididas pelas notas obtidas. Já fui Monitor de Microbiologia na graduação e sei o quanto é importante para aqueles que lutam por essas vagas. Hoje sou Professor de Microbiologia.
Houve também um comentário anônimo da Farmácia que eu destaco porque também percebi que durante as aulas remotas, as mesmas discentes estavam realizando outras tarefas. Percebia porque a minha aula era sempre interativa. Sempre parava e perguntava, de vez quando, algo do assunto a alguém especificamente. Houve um dia que estavam dentro de um laboratório. Nisso, uma delas alegou que estavam trabalhando. Parece que estavam fazendo o que nós chamados de Iniciação Científica. No mesmo instante coloquei: – Ou vocês participam da minha aula ou vão continuar seus trabalhos. Veja o comentário anônimo que o sistema permite que o aluno faça ao ingressar em um novo período (o que ocorreu 75 dias depois de terem terminado as aulas):
“Na parte de bacteriologia, foi tudo dado de forma superficial. Nas provas, era cobrado um nível que não foi dado em sala de aula. Além disso, o professor se mostrou duvidar da minha capacidade como aluna.”
A última frase sublinhada me chamou muito a atenção. Como foi anônimo o comentário, não posso afirmar nada. Mas me pareceu um ato bem pessoal e de alguém muito indignado por quase 3 meses depois de finalizado o período. Um ato...
xxx
Mas hoje minha esposa trouxe boas notícias. E me lembrei das inúmeras mensagens que recebi dos alunos da Biologia e da Farmácia.
RETORNANDO À HISTÓRIA INICIAL:
Quando minha esposa me contou sobre o "Juan" e "Jules", compreendi melhor sobre o que é ser PROFESSOR. Ser professor é amar JUAN e JULES, mesmo quando somos agredidos pelos juans de nossas trajetórias. Aí, nesse momento, quem perdeu algumas gotas de lágrimas fui eu, nos meus 56 anos de idade e nos mais de 30 anos de ensino.
MORAL DA HISTÓRIA:
Juan volta e decide aprender, apesar de suas limitações. Já o futuro professor ...
E a futura farmacêutica encontraram um atalho que pode torná-los menos humanos com o passar das décadas.
Mas o que eu tenho a vê com isso? Nem estarei mais caminhando na superfície desse maravilhoso planeta daqui há algumas décadas.
COMENTÁRIOS ENVIADOS VIA WHATSAPP DE DISCENTES QUE FREQUENTARAM NO MÍNIMO 80% DAS PRÁTICAS PRESENCIAIS E MAIS DE 90% DAS AULAS REMOTAS:
“Caramba professor, fiquei até chocada com o comentário desse aluno. O senhor foi sem dúvidas um excelente docente”
"A disciplina de microbiologia foi uma das melhores que cursei, super proveitosa.”
“Eu gostei mais desse método de avaliação porque tenho liberdade para escolher a parte dos conteúdos que chamou mais a minha atenção para discorrer sobre. Escrevendo até ajuda a fixar melhor o assunto abordado.”
“Achei a prova muito condizente com o que foi abordado em sala. As perguntas foram objetivas e tranquilas de se responder.”
“Eu gostei mais desse método de avaliação porque tenho liberdade para escolher a parte dos conteúdos que chamou mais a minha atenção para discorrer sobre. Escrevendo até ajuda a fixar melhor o assunto abordado.”
“Professor, muito obrigado por essa disciplina, apesar de eu ter sumido nos últimos dias por problemas, mas sem dúvidas eu gostei muito. Foi minha última disciplina de biologia do curso e vai deixar saudade certeza.”
“Eu refleti sobre a questão e acho que o termo organismo pode ser expandido nesse caso, n vi problemas.”
– Debate iniciado pelo professor Marcelo Moreno sobre usar a expressão organismo para partícula viral.
“A prova do prof. Dr. Marcelo Moreno feita via wpp foi tranquila porém me desencadeou uma ansiedade que eu raramente sinto ao fazer avaliações. Fiquei com receio da minha internet cair e ser prejudicada, e teve um momento onde o meu notebook travou a tela do google meet e eu só ouvia o prof dizendo que ia trocar a questão mas não via os slides. Então eu prefiro outros métodos de avaliação, apesar da prova ter sido mais tranquila do que pensei.”
"Você foi um excelente prof". Discente da Farmácia.
“Gostei bastante da disciplina, achei bem atualizada e condiz bastante com o presente, principalmente a parte da virologia nesse momento de pandemia.” Discente da Farmácia.
“Na minha opinião, as aulas práticas foram as melhores...estávamos reunidos presencialmente e você fez questão que todos os alunos praticassem o suficiente para "sair sabendo da aula". Independente de demorar ou não para aprender as técnicas.” Discente da Farmácia.
“ Eu gostei bastante da disciplina! Um ponto de destaque que eu achei é que foi uma matéria bem atual, abarcou o conteúdo programático do curso, mas não se limitou a isso, trouxe questões de atualidades principalmente em relação à pandemia. Os slides dão um bom norte do que estudar. Para as avaliações prestar atenção nas aulas, no que você pontua e seguir os slides (como roteiro de estudo) já ajuda muito, é suficiente para fazer uma boa avaliação. O seu tratamento para com os alunos foi excepcional sempre respeitoso e atento as nossas demandas.” Discente da Farmácia.
“Para minha pessoa em particular foi muito proveitoso nossa disciplina.”
“Boa noite, professor. Eu gostei muito do curso, ultrapassou minhas expectativas. Dentro dessa dinâmica que a pandemia trouxe, o senhor conseguiu conduzir a disciplina de forma leve e muito rica em conhecimento. As aulas práticas também foram cruciais para disciplina. Muito obrigada!”
“Ola, professor. Muito satisfeito. Gostei demais das aulas práticas.”
Sobre conversas dos conteúdos apresentados (debates provocados pelo professor):
“Eu achei bem pertinente o debate”. Discente da Farmácia.
COMENTÁRIOS SOBRE A PROVA que utilizou o WhatsApp:
“Professor, esse método me deixou bem nervoso, pois não foi o de costume, mas achei interessante devido ter sido abortado os assuntos dado em sala de aula (aula virtual).”
“ A prova foi muito interessante, achei um pouco confusa pois nunca tinha feito prova dessa maneira, como eu tenho um pouco de defit de atenção depois do intervalo teve uma hora que até esqueci que tava fazendo prova. Mas no geral achei interessante. Talvez poderia ter mais tempo pra responder pois, tiveram algumas questões com muito texto.”
“A prova foi condizente com o assunto visto em sala, mesmo quando não tratando de questões diretamente discutidas. Apesar do grande número de questões, eram de leitura rápida e possível de responder dentro do tempo estipulado. Os assuntos tratados foram atuais e interessantes.”
“A prova foi condizente com tudo oq foi passado em aula. E eu acho que foi em um bom nível sim. Eu só acho esse tipo de prova um pouco complicada, sendo que ela poderia ter sido mandada pelo Google forms ou algo do tipo. Mas quanto a conteúdo eu achei tranquilo.”
“Quanto aos assuntos abordado na prova, estiveram de acordo com o que havia sido trabalhado em sala de aula. Porém, a prova foi relativamente mais cansativa, já que a quantidade de questão e os textos foram maiores. No geral, tudo de acordo.” Discente da Farmácia.
FIM ?
Não. Só mais 1, enviado por um discente da Biologia:
“ Que triste os comentários que li! Mas infelizmenre é assim, sempre vai ter quem elogie e quem critique, o importante é não se deixar levar pelas críticas não construtivas. Como já falei, gostei muito da disciplina! As aulas práticas foram essenciais e a abertura que o senhor dava para os alunos realizarem os procedimentos certamente acrescentou muito na formação de todos os envolvidos. Fiquei muito triste quando chegou na última aula! A forma como foram conduzidas as aulas teóricas também foi boa, aprendi bastante e sem precisar sentir a sobrecarga que normalmente sentimos em boa parte das disciplinas.”
Acabei de receber mais dois comentários de discentes dessa mesma turma de Biologia. Colaram grau em dezembro do ano passado. Foi o último período deles. E, hoje, março de 2022, já estão empregados como professores de Biologia em um colégio na Paraíba. Veja:
Professor
“A disciplina de Microbiologia foi uma das minhas preferidas do curso. Os assuntos foram abordados de forma aprofundada, e apesar de ser uma disciplina densa não tive dificuldade de aprendizado.
As aulas práticas foram excelentes, as melhores do curso, pois fizemos varias atividades e sempre com bastante autonomia.
Essa foi minha última disciplina do curso e gostaria de agradecer ao professor pela disciplina e pelas práticas, pois sei que elas contribuíram muito para minha formação.”
WhatsApp enviado pelo ex-aluno e agora Professor em atividade: FIQUEI ATÉ ESPANTADO! Apesar do reconhecimento não era pra ser dessa forma. Analisem vcs mesmos!
Professora
“ Eu pude perceber que a microbiologia é uma disciplina muito prática, então não seria tão proveitoso se a disciplina tivesse sido apenas teórica, porque nós não conseguiríamos correlacionar os assuntos com o nosso cotidiano. Com a pandemia, muitos professores ainda tinham muito medo de voltarem para o período híbrido, e o senhor foi uma das poucas pessoas que abriram as portas do laboratório para que a gente conseguisse ter aulas práticas, e isso contribuiu muito com o meu aprendizado. Estou dando aula em uma escola de ensino médio e lecionei o assunto de bactérias, e fiz com os alunos uma prática de cultivo utilizando os conhecimentos adquiridos nas suas aulas, então só tenho a lhe agradecer pelas aulas que tanto contribuíram com o meu processo de aprendizado.”
VEJA RESULTADO FINAL DAS DUAS TURMAS, NOTAS E FALTAS (sem identificação do discente)
Veja a Biologia. Observe 7 alunos, num total de 18 com números atingindo quase o limite para reprovação por falta (16). Mesmo assim "passaram" direto sem a necessidade de Prova Final. Será que os vídeos e este relatório para esses que nunca assistiram a 1 única prática os auxiliou? SERIA ESSE PROFESSOR DE MICROBIOLOGIA irresponsável e insensível ?
xxx
Veja a Farmácia. A avaliação 2, precisei interromper, observei padrões de erros, acertos e tempo de resposta idênticos via WhatsApp nas duas primeiras discentes com nota 6. A primeira atingiu 18 faltas. O máximo é 20. Será que o professor não precisou abonar 1 dia de falta, para que esta discente não fosse reprovada por falta?
Resposta= Sim. Foi o que fiz, já que a discente obteve no final média 8,2. Preferi não ser tão rigoroso, mediante o desempenho. Até porque, todo material de apoio ficou disponível.
CONCLUSÃO
Compreendo que como professor precisamos cumprir nossa missão: fornecer um ambiente favorável para a aprendizagem. Além de revelar conteúdos que possam formar o melhor profissional para a sociedade. Durante todo o curso, através dos encontros remotos das aulas práticas e de todo conteúdo produzido para essa finalidade (esse relatório; mais de 10 vídeos no YouTube; e 3 artigos como primeiro autor em 1 deles e co-autor nos demais, onde procurei exibir a visão de 2 virologistas, um com 50 anos de experiência e outro, eu, com 30 anos de convivência com a Virologia, no objetivo de combater, cientificamente, a tão divulgada "falsa ciência" disseminada durante esse momento tão crítico para a humanidade.
Mas saber que hoje, março de 2022, dois professores do Estado da Paraíba, pertencentes a esta mesma turma de Biologia, já estão colocando em prática os conteúdos teóricos e práticos com seus alunos do ensino médio, muito me alegra. Receber essa notícia me faz sentir útil, e ter certeza de que a verdadeira Escola de Koch & Pasteur será perpetuada por esses colegas!
Mas não muito tempo, em dezembro de 2021, foram meus alunos.
 *Microbiologista trabalhando de acordo com a Escola de Pasteur. Operador com as mãos na frente do Bico de Bunsen.
*Microbiologista trabalhando de acordo com a Escola de Pasteur. Operador com as mãos na frente do Bico de Bunsen.

Comentários
Vocês ficam nos bastidores, mas são os verdadeiros astros!!!!
Todo profissional de sucesso é fruto de um mestre dedicado e competente.
Parabéns a vc e aos seus discentes, que estão sendo instruídos por um grande mestre e com certeza serão excelentes profissionais.
A opinião da maioria foi tão positiva e reconheceu o seu trabalho com louvor, que essa minoria pobre de espírito merece ser ignorada.
Mais uma vez meus parabéns!!!